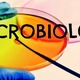
1.2

-
Aunque el origen del microscopio es una cuestión aún incierta, se le considera a Zacharias Janssen como el inventor del microscopio compuesto (con dos lentes), tal vez con la ayuda de su padre, en el año 1595.
-
La primera referencia segura sobre el microscopio (1621) se debe a Constantijn Huygens, quien relata que el inglés Cornelis Drebbel tenía en su taller un instrumento magnificador, que recibió el nombre de "microscopium" en 1625, en la Accademia dei Lincei, de Roma.
-
Francesco Redi demostró que los insectos no nacen por generación espontánea, por lo que se le considera el fundador de la helmintología (el estudio de los gusanos). Realizó estudios sobre el veneno de las víboras, y escribió Observaciones en torno a las víboras (1664).
-
Jugo un papel importante en a revolución científica, a traves de trabajos experimentales y teoricos. Su principal aporte fué su famoso libro Micrographia, publicadp en 1665, que fue el primero dedicado a observaciones microscópicas, Hooke describió, entre otras cosas, los cuerpos fructificantes de los mohos.
-
Utiliza unos botes de cristal con trozos de carne, dichos botes los tapa con unas gasas que permiten el paso del aire pero de nada más, entonces no se generan "animáculos" en estos trozos de carne. La solución está en las larvas que son depositadas por moscas que se posaban en la carne, en los botes sin tapar, y hacían posible la aparición de esos "animáculos"
-
Realizó la primera descripción precisa de los glóbulos rojos en 1674 Fue el primero en realizar importantes observaciones con microscopios fabricados por él mismo. Desde 1674 hasta su muerte realizó numerosos descubrimientos. Fue el precursor de la biología experimental, la biología celular y la microbiología.
-
En una carta fechada el 25 de abril de 1679, ofrece la que probablemente sea la primera estimación de la población máxima que podría alcanzar la Tierra. Se basa en la densidad de Holanda en su época (120 personas por kilómetro cuadrado), y considera que la Tierra podría acoger hasta 13,4 mil millones de seres humanos.
-
Le apasionó el problema de la regeneración espontánea de partes del cuerpo de anfibios y de reptiles aunque no pudo llegar a conclusiones satisfactorias, sobre todo no pudo explicar el por qué no sucedía lo mismo en el ser humano y en otros animales.
-
El descubrimiento de la vacuna antivariólica enconrada por Edward Jenner (1749-1823); tuvo trascendencia definitoria para combatir la viruela, enfermedad que se había convertido en una terrible epidemia en varios continentes.
-
Bassi demuestra que la muscardina era provocada por un cierto tipo de hongo que nombra Botrytis paradoxa (actual Beauveria bassiana, Vuillemin, 1912) . A esta Beauveria bassiana se la nombra en su homenaje.
-
La teoría microbiana fue muy controvertida en sus inicios, hoy en día es fundamental en la medicina moderna y la microbiología clínica y condujo a innovaciones tan importantes como el desarrollo de vacunas, los antibióticos, la esterilización y la higiene como métodos efectivos de cura y prevención contra la propagación de las enfermedades infecciosas.
-
Berkeley es considerado padre de la Micología británica; llegando a describir muchísimas especies. Su herbario de cerca de 10 000 especies de champignones (con alrededor de 5 000 que describe) se conservan en las colecciones de los Reales Jardines Botánicos de Kew. Descubre un hongo (Phytophthora infestans) que produce la podredumbre de la patata.
-
Eichstedt describió por primera vez el componente micótico de las lesiones de la pitiriasis versicolor.La pitiriasis versicolor es una enfermedad infecciosa de la piel, comúnmente causada por hongos del género Malassezia, que agrupa especies de levaduras dimórficas lipofílicas que forman parte de la flora cutánea normal
-
El médico húngaro Ignacio Felipe Semmelweis realizó entre 1847 y 1856 una serie de estudios epidemiológicos en la Maternidad de Viena que le llevaron a la conclusión de que la causa estribaba en una higiene deficitaria de los médicos que asistían a las parturientas. La mortalidad por esta enfermedad en la época de Semmelweis rozó en algunos momentos el 96%
-
Desarrolló mediante calor la práctica quirúrgica de la asepsia y la antisepsia, mejorando notablemente la situación postoperatoria de los pacientes.
Gracias al descubrimiento de los antisépticos en 1865, Lister contribuyó a reducir en gran medida el número de muertes por infecciones contraídas en el quirófano después de que los pacientes fueran sometidos a intervenciones quirúrgicas. -
Fueron descubiertos por Friedrich Meischer que los llamó NUCLEINA ya que los aisló del núcleo celular.
-
Para encontrar el moderno concepto de asepsia hay que ubicarse en el s. XIX. Semmelweis demuestra que el lavado de las manos antes de atender un parto reduce la fiebre puerperal. Luego de las sugerencias de Louis Phillips, Spencer Lister introduce el uso del ácido carbólico como desinfectante de cirugía. Lawson Tait va de la antisepsia a la asepsia, introduciendo principios y prácticas que aún son válidas hoy.
-
Aisló varias moléculas ricas en fosfatos, a las cuales llamó nucleínas (actualmente ácidos nucleicos), a partir del núcleo de los glóbulos blancos en 1869, y así preparó el camino para su identificación como los portadores de la información hereditaria, el ADN.
-
Propuso la clasificación de las bacterias: género, especie y variedades.
Describió otros microorganismos patógenos transmitidos por agua contaminada. -
Fue un microbiólogo alemán a quien se le atribuye la invención de la placa de Petri, mientras trabajaba como asistente de Robert Koch.
En 1877 cuando inventó la placa Petri. Esta se utiliza en los laboratorios principalmente para el cultivo de microorganismos, soliéndose cubrir el fondo con distintos medios sólidos de cultivo según el microorganismo que se quiera cultivar. -
Carlos J. Finlay descubrió a finales del siglo XIX que el mosquito Aedes Aegyti era el trasmisor de la fiebre amarilla
-
Se hizo famoso por descubrir el bacilo de la tuberculosis en 1882; presenta sus hallazgos el 24 de marzo de 1882. Es considerado el fundador de la bacteriología.
-
El bacilo del cólera en 1883 y por el desarrollo de los postulados de Koch. Recibió el Premio Nobel de Medicina en 1905.
-
Es la tinción diferencial empleado en bacteriología para la visualización de bacterias, sobre todo en muestras clínicas. Debe su nombre al bacteriólogo danés Christian Gram, que desarrolló la técnica en 1884. Se utiliza tanto para poder referirse a la morfología celular bacteriana, como para poder realizar una primera aproximación a la diferenciación bacteriana, considerándose bacterias gram positivas a las que se visualizan de color morado, y bacterias gram negativas.
-
En 1888, se ubica en Zúrich, donde arranca una investigación en los procesos de la nitrificación, identificando los géneros Nitrosomonas y Nitrosococcus, ambas oxidan amonio a nitrito, y Nitrobacter, que oxida nitrito a nitrato.
-
Haemophilus influenzae, anteriormente llamado bacilo de Pfeiffer o Bacillus influenzae, son cocobacilos Gram-negativo no móviles descritos en 1892 por Richard Pfeiffer durante una pandemia de gripe. Sin embargo, H. influenzae es responsable de un amplio rango de enfermedades como meningitis, epiglotitis, neumonía, sepsis y otras de menor gravedad.
-
Vinogradski es conocido por descubrir la quimioautotrofía, el proceso por el cual los organismos derivan energía de un número de compuestos diferentes inorgánicos, obteniendo carbono en la forma de dióxido de carbono.
-
El bacteriólogo británico Alexander Fleming debe su fama al descubrimiento de la penicilina, un antibiótico que revolucionó la medicina moderna. La utilización de esta sustancia permite tratar diversas enfermedades que, hasta bien entrado el siglo XX, se consideraban incurables.
-
El 12 de junio de 2009, cuando el grupo farmacéutico suizo Novartis, con el apoyo económico del gobierno de Estados Unidos, anunció haber producido el primer lote de vacunas contra el virus. Los ensayos clínicos para la obtención de la licencia de la vacuna se realizaron en julio del 2010, para poder iniciar la producción en masa de la vacuna y su posterior distribución.
-
Bruce Ames pone a punto un test bacteriano para detectar mutágenos y carcinógenos: el test de Ames.
El test de Ames es un ensayo biológico para evaluar el potencial mutagénico de compuestos químicos. Puesto que el cáncer está vinculado a menudo con el daño de el ADN, la prueba también sirve como un ensayo rápido para estimar el potencial cancerígeno de un compuesto, ya que las pruebas estándar para la carcinogenicidad hechas sobre roedores toman años para completarse y son caras de realizar.
A list shows items. A timeline shows sequence.
Use Timetoast to make dates, milestones, and turning points easier to understand in a clear visual format. Timetoast is a timeline maker for work, school, research, and stories.